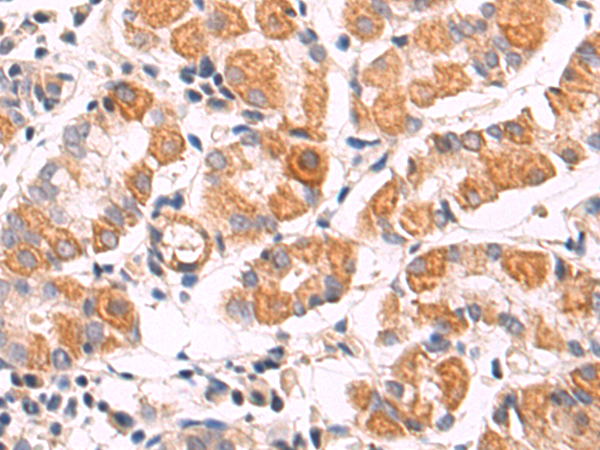

-
分类: 科研抗体货号: P05998别名: PYM; WIBG应用: IHC反应种属: Human, Mouse
-
分类: 科研抗体货号: P05945别名: CFND; CFNS; EFB1; EFL3; EPLG2; Elk-L; LERK2应用: IHC反应种属: Human, Mouse, Rat
-
分类: 科研抗体货号: P05898别名: MKS12应用: WB,IHC反应种属: Human
-
分类: 科研抗体货号: P05996别名: WAP2; SWAM2; C20orf122; dJ211D12.4应用: IHC反应种属: Human
-
分类: 科研抗体货号: P05944别名: TSBP; p150; SH2BP1; p150TSP应用: IHC反应种属: Human, Mouse
-
分类: 科研抗体货号: P05893别名: IRAK; pelle应用: WB,IHC反应种属: Human
-
分类: 科研抗体货号: P05990别名: XT1; XTI; XT-I; DBQD2; XYLTI; PXYLT1; xylT-I应用: WB,IHC反应种属: Human, Mouse, Rat
-
分类: 科研抗体货号: P05938别名: AC2; HBAC2应用: WB,IHC反应种属: Human, Mouse, Rat
-
分类: 科研抗体货号: P05892别名: SLEB10应用: IHC反应种属: Human, Mouse
-
分类: 科研抗体货号: P05988别名: XLF应用: WB,IHC反应种属: Human, Mouse, Rat

鄂公网安备42018502007531号
鄂公网安备42018502007531号

